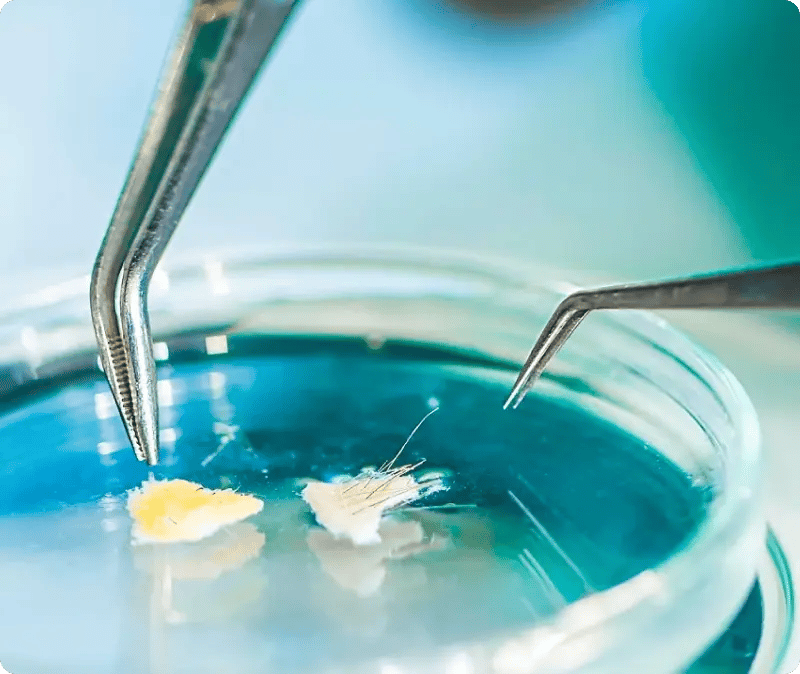
pierre-fabre-sag-helt

Blended learning, der løfter apoteksalget
Pierre Fabre Dermo-Cosmétique har gennem flere år opbygget et akademi for farmakonomer for at styrke rådgivning, service og salg.
De vigtigste pointer
Salget går op
Apoteker med deltagere i programmet oplever højere salg end apoteker, der ikke deltager.
Struktureret akademiforløb
Et årelangt forløb med titel og diplom gør læringen mere sammenhængende og lettere at gennemføre.
Viden, der sidder fast
Historiebaserede moduler gør kompleks viden lettere at huske og bruge i mødet med kunder.
Fremdrift og udvikling
Interaktive opgaver og belønninger holder deltagerne i gang hele vejen gennem forløbet.
Om Pierre Fabre
Pierre Fabre Dermo-Cosmétique er det næststørste private medicinalfirma i Frankrig og det næststørste dermokosmetiske laboratorium på verdensplan. Porteføljen spænder over receptpligtig medicin, håndkøbsprodukter og dermokosmetik, herunder Eau Thermale Avène, A-Derma, Ducray og Klorane.
Udfordringen
Pierre Fabre Dermo-Cosmétique sælger produkter gennem apoteker, fordi de gerne vil have, at kunderne får professionel rådgivning. Det forudsætter, at farmakonomer opbygger en dybere viden om huden, kundernes behov og produkterne, så de kan give god vejledning og service.
Tidligere blev uddannelsen ofte leveret som store aftensarrangementer uden for arbejdstiden. Deltagelses- og fastholdelsesgraden var ikke, hvor som de skulle være, og formatet skabte ikke en konsekvent effekt i det daglige arbejde på apoteket. Pierre Fabre havde brug for et læringssetup, der kunne engagere deltagerne, hjælpe dem med at bruge viden i rigtige samtaler og skalere uden at være afhængigt af engangsarrangementer.
Kamilla Greisen Bacher
Nordisk marketingdirektør, Pierre Fabre Dermo-Cosmétique

Løsningen
Kamilla Greisen Bacher og den danske kommercielle chef har skabt et årelangt uddannelsesforløb, der dækker hudkendskab, forbrugerbehov og produktforståelse. Deltagerne får en titel og et diplom ved afslutningen, hvilket er med til at gøre uddannelsen til en struktureret rejse i stedet for en enkelt begivenhed.
Learningbank har hjulpet med at strukturere og styre hele processen og har bygget den digitale platform til Pierre Fabre Academy. Et kerneelement er et historiebaseret modul, hvor deltageren rejser gennem Pierre Fabres historie og DNA, mens han eller hun løser interaktive udfordringer. Rejsen bruger opgaver og belønninger til at holde fokus og skabe fremdrift, og den er bundet til det praktiske mål: bedre rådgivning og bedre service på apoteket.

Resultaterne
Uddannelsen bliver modtaget med meget stærk feedback, og der er blandt andet begejstring for de digitale moduler og oplevelsen af at gennemføre dem. Det er vigtigt, fordi engagement var en del af udfordringen med den tidligere eventbaserede tilgang.
Efter deltagerne havde bestået eksamenerne, analyserede Pierre Fabre salgsresultaterne. Pierre Fabres salg ind i apotekerne steg dobbelt så meget på apoteker med en deltager i programmet som på apoteker uden deltagelse. I samme periode steg salget til forbrugere tre gange mere på apoteker med en deltager sammenlignet med året før.
Internt får det nordiske datterselskab en stærkere position som frontløber inden for digital læring. Programmet og resultaterne bliver delt med internationale datterselskaber, hvilket fører til interesse for at kopiere og oversætte de digitale moduler.
"Vi præsenterede træningen og de digitale moduler internt for direktørerne i alle de internationale datterselskaber, og de var fuldstændig blæst bagover af både design og resultater. Nu får vi konkrete forespørgsler fra andre lande, som er meget interesserede i at kopiere de digitale moduler og oversætte dem."
Kamilla Greisen Bacher
Nordisk marketingdirektør, Pierre Fabre Dermo-Cosmétique
Vil du vide mere?
Gør træning til ensartet praksis i hverdagen. Reducér onboarding-tiden, gør indholdsopdateringer nemme, og udrul træning på tværs af roller, lokationer og sprog.

Flere historier fra den virkelige verden
Udforsk, hvordan andre teams reducerer administrationstiden, fremskynder onboarding og holder standarderne ensartede

Gør det muligt for teams at arbejde effektivt
Giv dine frontlinjearbejdere de værktøjer, de har brug for.

Læring i arbejdsflowet
Optimer dine produktionsprocesser, og sørg for, at sikkerheden overholdes.

Spar tid og penge med interaktive læringsspil
Øg gæsternes tilfredshed ved at udstyre dit personale med den rette viden og de rette færdigheder.
Få en praktisk demonstration, ikke en præsentation
Vil du se, hvordan en Workforce Enablement Platform fungerer i praksis? Book en demo og oplev, hvordan Learningbank understøtter onboarding, læring i hverdagen og lederopfølgning – så træning skaber ensartethed og bedre resultater i stor skala.
250k